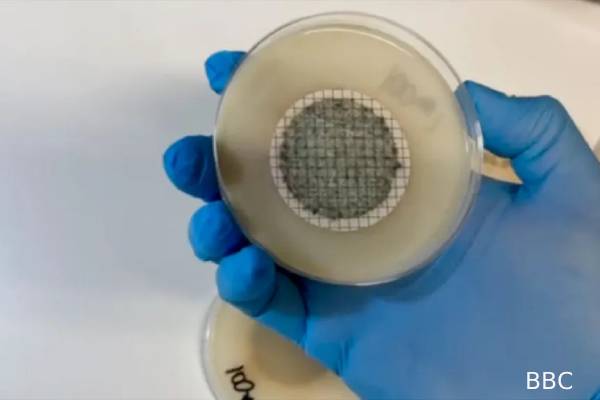
தேம்ஸ் நதியில் பயங்கர கிருமிகள்: ஆய்வாளர்கள் எச்சரிக்கை | Antibiotic Resistant Bacteria Found Thames River தேம்ஸ் நதியில் பயங்கர கிருமிகள்: ஆய்வாளர்கள் எச்சரிக்கை | Antibiotic Resistant Bacteria Found Thames River

தேம்ஸ் நதியில் பயங்கர கிருமிகள்: ஆய்வாளர்கள் எச்சரிக்கை
இன்றைய உலகில், நோயாளிகளின் உயிரிழப்புக்கு அதிக அளவில் காரணமாக இருக்கும் நோய்க்கிருமிகளில், Antibiotic-resistant bacteria என அழைக்கப்படும் கிருமிகள் முக்கியப் பங்கு வகிக்கின்றன.
பயங்கர கிருமிகள் என்றால் என்ன?
இந்த Antibiotic-resistant bacteria என்பது என்ன என்று சுருக்கமாக பார்க்கலாம். அதாவது, ஒரு மனிதனுக்கு ஒரு குறிப்பிட்ட வகை கிருமியால், உதாரணமாக பாக்டீரியா என்னும் நோய்க்கிருமியால் ஒரு நோய் உருவாகியுள்ளது என வைத்துக்கொள்வோம்.
அந்த நோயாளிக்கு, ஆன்டிபயாட்டிக் என்னும் மருந்தைக் கொண்டு சிகிச்சையளிப்பார்கள்.

அதே நேரத்தில், ஒரு நோயாளிக்கு வைரஸ் தோற்று ஏற்பட்டுள்ளது என்றால், சில வகை தொற்றுகளுக்கு ஆன்டிவைரல் மருந்துகள் உள்ளன.
அதேபோல, நோயுண்டாக்கும் பூஞ்சையால் நோய்த்தொற்று உருவாகியிருந்தால், அதற்கு சிகிச்சையளிக்க ஆன்டிஃபங்கல் என்னும் வகை மருந்துகள் பயன்படுத்தப்படும்.
ஆக, ஒரு நோயாளிக்கு பாக்டீரியா தொற்று உருவாகியிருந்தால், அவருக்கு ஆன்டிபயாட்டிக் என்னும் மருந்து கொடுக்கப்படும்.
இந்த ஆன்டிபயாட்டிக் என்னும் மருந்தை நோயாளி உட்கொள்ளும்போது, அது, அந்த நோயாளியின் உடலுக்குள் சென்று அந்த குறிப்பிட்ட கிருமியை கொன்றுவிடும்.
விடயம் என்னவென்றால், மனிதன் தன்னை காலத்துக்கும் சூழ்நிலைக்கும் ஏற்ப மாற்றிக்கொள்வதைப்போல, சிலவகை கிருமிகளும் தங்களை மாற்றிக்கொள்கின்றன. அதாவது, ஆன்டிபயாட்டிக்கையே எதிர்க்கும் வகையில் சில கிருமிகள் மாறிவிடுகின்றன.
அப்படிப்பட்ட கிருமிகளால் தொற்று ஏற்பட்டால், அவற்றிற்கு சிகிச்சையளிக்க ஆன்டிபயாட்டிக் கொடுத்தாலும், அது அந்த நோயாளிக்கு வேலை செய்யாது. விளைவு, மரணம் கூட ஏற்படலாம்.
இத்தகைய கிருமிகள்தான் Antibiotic-resistant bacteria என அழைக்கப்படுகின்றன.
2019ஆம் ஆண்டில் மட்டும், இந்த Antibiotic-resistant bacteria தொற்றால், 1.27 மில்லியன் நோயாளிகள் உயிரிழந்தார்கள். 2050இல், இந்த எண்ணிக்கை ஆண்டுக்கு 10மில்லியனாக உயரும் (அந்த எண்ணிக்கை புற்றுநோயால் உயிரிழப்பவர்களுடைய எண்ணிக்கையை விட அதிகம்) என கணக்கிடப்பட்டுள்ளது.
ஆகவேதான், அவற்றை பயங்கர கிருமிகள் என்கிறோம்!
தேம்ஸ் நதியில் பயங்கர கிருமிகள்
இந்நிலையில், அந்த ’பயங்கர’ நோய்க்கிருமி தொடர்பில் அதிர்ச்சியை உருவாக்கும் செய்தி ஒன்றை ஆய்வாளர்கள் சிலர் வெளியிட்டுள்ளார்கள்.
தேம்ஸ் நதி நீரில் கடந்த ஆண்டு மேற்கொள்ளப்பட்ட ஆய்வில், 100 மில்லிலிற்றர் நீரில், இந்தவகை கிருமிகள் 1,070 இருந்தது தெரியவந்தது.

மீண்டும் இந்த மாதம் ஆய்வு மேற்கொண்டபோது, தேம்ஸ் நதி நீரில், 100 மில்லிலிற்றர் நீரில் 8,600 அதே வகை கிருமிகள் இருப்பது தெரியவந்துள்ளது.
சிறிய அளவு நீரில் மேற்கொள்ளப்பட்ட ஆய்வே இப்படி ஒரு அதிர்ச்சியளிக்கும் முடிவுகளைக் கொடுக்கும் என்றால், தேம்ஸ் நதியில் பெரிய அளவில் ஆய்வுகள் மேற்கொண்டால் விளைவுகள் எப்படி இருக்கும் என்கிறார் ஆய்வை தலைமையேற்று நடத்திய Dr Rob Morley என்பவர்.
ஆக, தேம்ஸ் நதியில் குளிப்பவர்களுக்கு இந்த கிருமிகளால் பாதிப்பு ஏற்படலாம் என எச்சரிக்கிறார் அவர்.
| உள்நாட்டு மற்றும் வெளிநாட்டு செய்திகளை உடனுக்குடன் அறிந்துக்கொள்ள லங்காசிறி WHATSAPP CHANNEL இல் இணையுங்கள் |